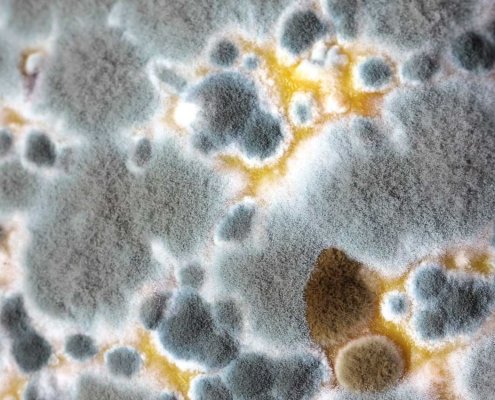
The dangers of mould in the home

Blog Posts
The 20 latest Blog Posts
- The Essential Guide to Artificial Grass Cleaning: Benefits, Risks, and Why TurfGlo is Australia’s Trusted Choice
- The Importance of Regular Turf Cleaning and Why TurfGlo is Australia’s Leading Turf Maintenance Solution
- Artificial Grass Cleaner: Choosing the Right Professional
- Turf Cleaning: Keep Your Artificial Grass Fresh and Inviting
- Reasons for Mold on Artificial Turf and What to Do About It
- Keeping Your Artificial Grass Pristine: Essential Maintenance Tips
- Maintaining Your TurfGlo Lawn in the Australian Winter
- The Ultimate Guide to Protecting Your Home’s Artificial Turf in the Winter
- Pre-Winter Prep: Getting Your Artificial Turf Ready for Winter
- Post-Winter Revival: Bringing Your Artificial Turf Back to Life
- Allergens on Artificial Grass
- How often should I clean my artificial grass
Portfolio
The 8 latest Portfolio Entries
Pages
Available Pages
- Affiliate
- Artificial Turf Maintenance Services for Armadale – Melbourne VIC
- Artificial Turf Maintenance Services for Balwyn – Melbourne VIC
- Artificial Turf Maintenance Services for Brighton – Melbourne VIC
- Artificial Turf Maintenance Services for Canterbury – Melbourne VC
- Artificial Turf Maintenance Services for Hawthorn – Melbourne VIC
- Artificial Turf Maintenance Services for Kew – Melbourne VIC
- Artificial Turf Maintenance Services for Malvern – Melbourne VIC
- Artificial Turf Maintenance Services for South Yarra – Melbourne VIC
- Artificial Turf Maintenance Services in Albert Park – Melbourne VC
- Artificial Turf Maintenance Services in Albert Park – Melbourne VIC
- Artificial Turf Maintenance Services in Beaumaris – Melbourne VIC
- Artificial Turf Maintenance Services in Bentleigh – Melbourne VIC
- Artificial Turf Maintenance Services in Black Rock – Melbourne VIC
- Artificial Turf Maintenance Services in Brighton East – Melbourne VIC
- Artificial Turf Maintenance Services in Camberwell – Melbourne VIC
- Artificial Turf Maintenance Services in Canterbury – Melbourne VIC
- Artificial Turf Maintenance Services in Caulfield – Melbourne VIC
- Artificial Turf Maintenance Services in Caulfield South – Melbourne VIC
- Artificial Turf Maintenance Services in East Melbourne VIC
- Artificial Turf Maintenance Services in Elsternwick – Melbourne VIC
- Artificial Turf Maintenance Services in Elwood – Melbourne VIC
- Artificial Turf Maintenance Services in Glen Iris – Melbourne VIC
- Artificial Turf Maintenance Services in Hampton – Melbourne VIC
- Artificial Turf Maintenance Services in Hampton East – Melbourne VIC
- Artificial Turf Maintenance Services in Hawthorn East – Melbourne VIC
- Artificial Turf Maintenance Services in Highett – Melbourne VIC
- Artificial Turf Maintenance Services in Kooyong – Melbourne VIC
- Artificial Turf Maintenance Services in McKinnon – Melbourne VIC
- Artificial Turf Maintenance Services in Middle Park – Melbourne VIC
- Artificial Turf Maintenance Services in Ormond – Melbourne VIC
- Artificial Turf Maintenance Services in Port Melbourne – VIC
- Artificial Turf Maintenance Services in Prahran – Melbourne VIC
- Artificial Turf Maintenance Services in Richmond – Melbourne VIC
- Artificial Turf Maintenance Services in Sandringham – Melbourne VIC
- Artificial Turf Maintenance Services in Windsor – Melbourne VIC
- ATP Testing for Artificial Grass Cleaning
- ATP Testing for Artificial Grass Cleaning
- Basic Clean
- Basic Clean
- Before and after initial draft
- Best Grass Installation | TurfGlo Expert Turf Solutions
- Body Corp, Hospitality and Real Estate
- calc test
- Careers
- Cart
- Checkout
- contact us
- Doggy day care
- Express Clean
- FAQ
- Fitness Centres
- Free Site Assessment
- Gallery
- Gallery – Before & After
- Get Started
- Happy Turfs
- Home New -sandi
- Home New (Elementor)
- Insurance
- Know About Turfglo
- Maintenance Mode
- Mini Clean
- page tester 2
- Pet Lovers
- PlaySafe Turf Care
- Premium Clean
- Premium Turf Clean
- Pricing
- Privacy Policy
- Professional Turf Leveling & Repair Services
- Protect and Revitalize Your Turf with TurfGlo Shield — Melbourne
- Protect and Revitalize Your Turf with TurfGlo Shield — Now in Brisbane
- Schedule Service
- Schools and Day Cares
- Science Behind Turfglo
- Service Area for Greater Geelong and Surf Coast
- Service Area for Maroondah, Knox, Manningham, Monash, Whitehorse & Yarra Ranges
- Service Area for Moonee Valley, Maribyrnong, Hobsons Bay, Hume, Brimbank, Melton, Wyhndam & Whittlesea
- Service Area for Mornington Peninsula, Frankston, Casey, Dandenong & Cardinia
- Service Area for Port Phillip, Bayside, Kingston, Melbourne CBD, Yarra, Boroondara, Glen Eira, Stonnington, and Manningham
- Service Areas
- Standard
- Terms & Conditions
- TESTING Basic Clean
- Thank You
- Tips
- Turf Replace
- TurfGlo Australia | Premium Turf Solutions & Lawn Care Products
- Turflgo spray
- Ultimate Care
- Warranty
Categories
Archives by Subject:
Monthly